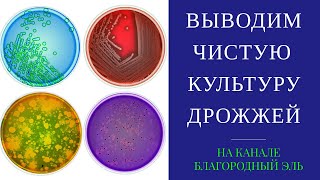
видео: Выращивание чистой культуры пивных дрожжей в домашних условиях. Повторное использование дрожжей. картинка: Выращивание чистой культуры пивных дрожжей в домашних условиях. Повторное использование дрожжей.

Как сохранить дрожжи после брожения - сбор и сохранение дрожжей для повторного использования
Показываю свой способ сбора и сохранения пивных дрожжей после брожения для их повторного использования. Не надо каждый раз покупать свежие дрожжи, чтобы поставить брагу. Достаточно собрать их после брожения по этой схеме и хранить в холодильнике. При следующей постановке браги, собранные дрожжи надо достать из холодильника и разбродить. Дальше добавляем их в затор или сусло и они прекрасно бродят. Этот процесс можно повторять несколько раз с неизменно хорошим результатом. #дрожжи #самогоноварнеие #пивоварение #пиво #каксохранитьдрожжи Tiktok: / kdiletant Яндекс Дзен: https://zen.yandex.ru/id/6001bc4be143...
Instagram: / kdiletant